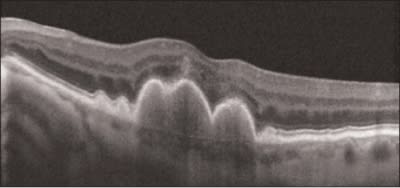

Cirrus HD-OCT Today and Tomorrow
Upcoming analysis capabilities complement unsurpassed image quality and ease of use.

By Carmen Puliafito, MD, MBA
In the past year, spectral domain optical coherence tomography (SD-OCT) has continued to evolve, further expanding its utility in the ophthalmic practice. In this article, I highlight key capabilities specific to the Cirrus HD-OCT (Carl Zeiss Meditec, Dublin, Calif.). Next, three fellow ophthalmologists describe how these capabilities enhance their glaucoma and retina practices, and they provide a preview of exciting features to come.
Ease of Use
One of the tremendous assets of Cirrus HD-OCT is its ease of use. Images can be captured readily by physicians and practice technicians. Viewing the fundus is not necessary for pre-scan focusing. Instead, focus is accomplished through a much simpler iris viewer.
The image acquisition speed of the instrument also sets it apart from other available systems. Once the patient's eye is in focus, a full scan is obtained in approximately 2 seconds. The ability to image the retina so quickly contributes to smooth and efficient patient flow.
The Cirrus HD-OCT has a small footprint and, therefore, fits easily into any practice layout, even when space is tight. The technician and patient sit 90 degrees apart, which means the technician can easily see the patient throughout testing, and the instrument can be placed in the corner of a room.
Information-Packed Reports
The speed of the Cirrus HD-OCT not only contributes to practice efficiency, it also gives the system its ability to capture a high-density cube of data. In general, I prefer reviewing OCT results in real-time via a live connection and computer monitor. Many physicians, however, prefer to work from the printout. Cirrus HD-OCT printouts (Figure 1) display the most clinically relevant data in images and maps.

Figure 1. Cirrus HD-OCT printouts display the most clinically relevant data in images and maps.
The macular thickness printout, for example, shows the line scanning ophthalmoscope (LSO) fundus image. That image can be overlayed with either the macular thickness map or the OCT fundus image, both of which are also shown separately. The macular thickness map topographically illustrates the thickness between the internal limiting membrane (ILM) and the retinal pigment epithelium (RPE). The OCT fundus image is the surface view of the 6x6-mm cube of data. (Simultaneous capture of the OCT and the LSO fundus images ensures precise registration between the OCT scan and the fundus image.) The printout also includes the ILM and RPE layers segmented out, so their condition can be seen at a glance.
Two high-definition crosshair images on the printout provide enhanced resolution in the center of the scan, which is usually the area of interest. Central subfield thickness, total volume and overall average thickness over the entire 6x6-mm scan area are displayed in a table. A circular map provides overall average thickness values in each of nine sectors.
Enhanced HD 5-Line Raster Scan
The 5-line raster scan is the Cirrus HD-OCT's highest density scan. It consists of 4,096 A-scans in each of the five lines. The length, angle and spacing between the lines can be adjusted to acquire the best view of the area of interest.
The 5-line raster scan, which allows visualization of the fine details of the retinal structure, has recently been improved. With what is known as Selective Pixel Profiling, the new scan protocol collects more data per scan location than the other Cirrus scans and then evaluates all of the pixel data to construct the best possible image (Figure 2). It leverages the scan engine's capabilities to produce images with outstanding detail without impacting the patient workflow.
Figure 2. Enhanced HD Scan from the Cirrus HD-OCT.
New Capabilities Improve Care
The next three articles further describe how the advanced features of the Cirrus HD-OCT are helping ophthalmologists better diagnose and manage glaucoma, age-related macular degeneration (AMD) and diabetic retinopathy.
They also describe some impressive new capabilities in the areas of glaucoma progression, which are available now, and dry AMD analysis, which will be added to the system soon.
Dr. Puliafito is dean of the University of Southern California's Keck School of Medicine, where he also serves as a professor of Ophthalmology and Health Management.








